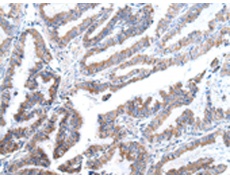
一抗

中文名稱:兔抗XKR4多克隆抗體
英文名稱: Anti-XKR4 rabbit polyclonal antibody
別 名: XRG4
相關(guān)類別: 一抗
儲 存: 冷凍(-20℃)
抗 原: XKR4
宿 主: Rabbit
反應(yīng)種屬: Human, Mouse, Rat
標 記 物: Unconjugate
克隆類型: rabbit polyclonal
技術(shù)規(guī)格
|
Background: |
XKR4 (XK-related protein 4) is a 650 amino acid multi-pass membrane protein that likely is a component of the XK/Kell complex of the Kell blood group system. The gene encoding XKR4 maps to human chromosome 8, which is made up of nearly 146 million bases and encodes about 800 genes. Single nucleotide polymorphisms (SNPs) of the XKR4 gene are associated with iloperidone efficacy, a antipsychotic drug that is used to treat schizophrenic patients. |
|
Applications: |
ELISA, IHC |
|
Name of antibody: |
XKR4 |
|
Immunogen: |
Synthetic peptide of human XKR4 |
|
Full name: |
XK, Kell blood group complex subunit-related family, member 4 |
|
Synonyms: |
XRG4 |
|
SwissProt: |
Q5GH76 |
|
ELISA Recommended dilution: |
2000-5000 |
|
IHC positive control: |
Human esophagus cancer |
|
IHC Recommend dilution: |
20-100 |

 購物車
購物車 幫助
幫助
 021-54845833/15800441009
021-54845833/15800441009